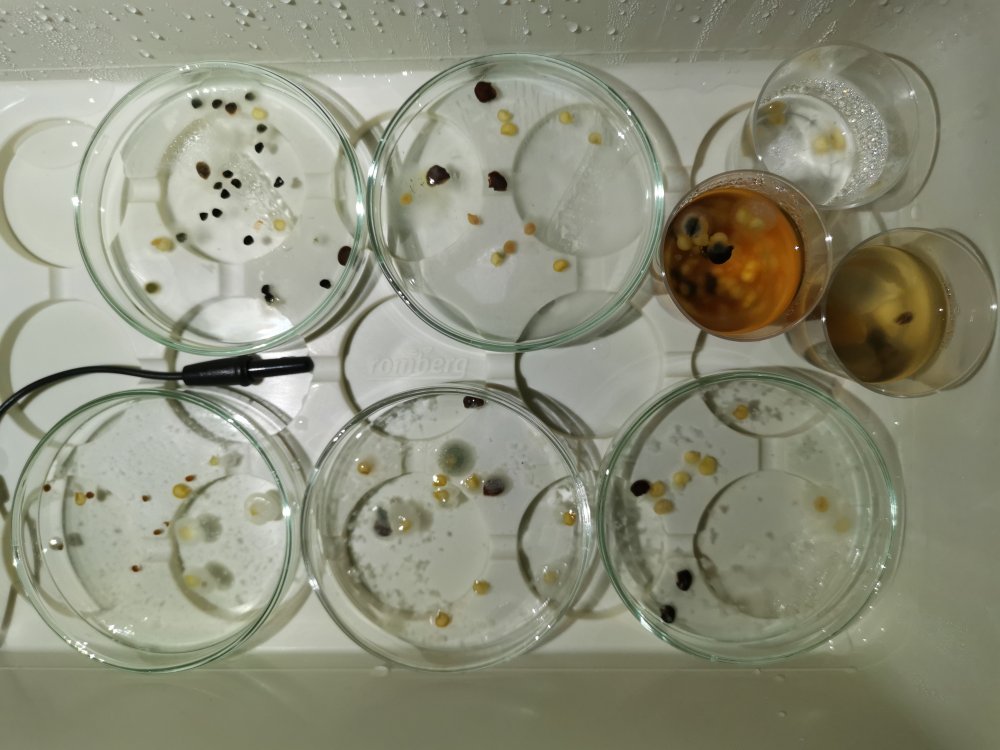
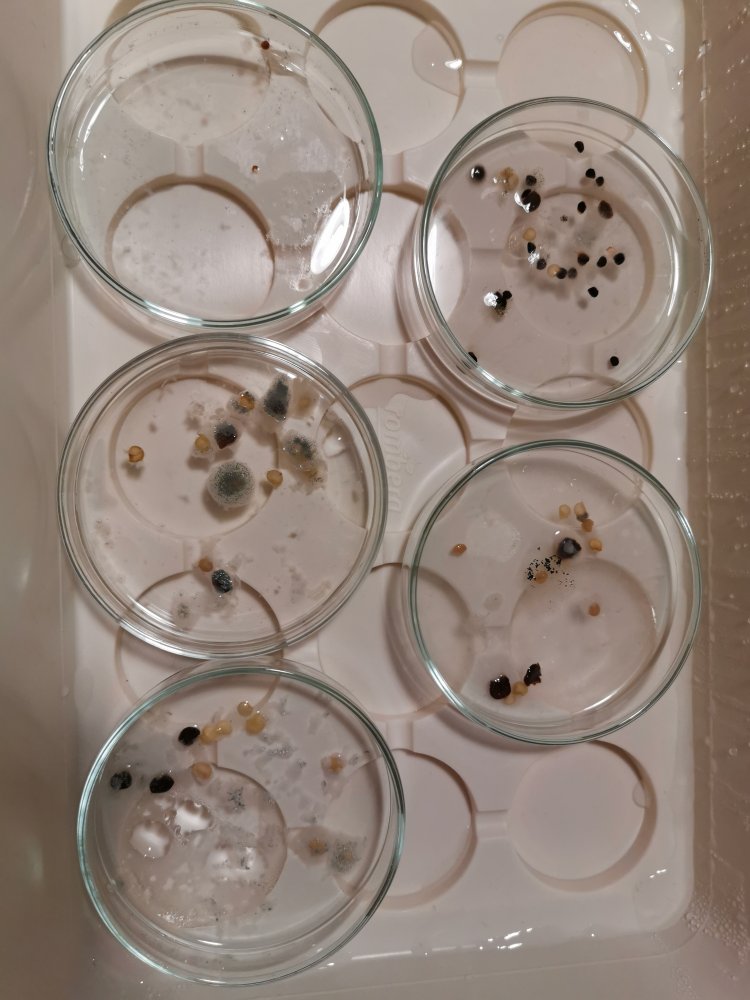
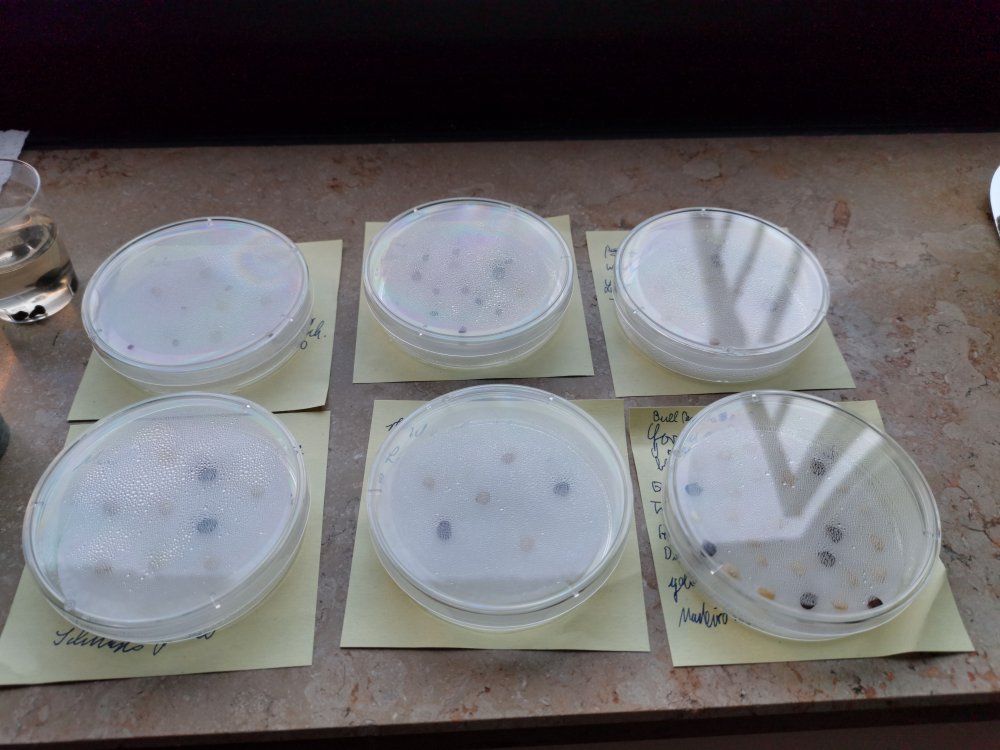

- Beiträge
- 599
Kleines Update nach knapp einer Woche im Wasserbad mit GA 3 und ohne Licht hat sich trotz konsequenten lüften Schimmel gebildet.
Werde nun bald die Samen säubern und dann in Erde pflanzen.
Mal wieder zu viel gewollt, obwohl keimen in Wasser mit Schnappsgläser fast immer ohne Schimmel geklappt hat.
Nur bei den Petrischalen nicht. Liegt wohl an zu wenig Wasserdruck pro mm, was Schimmel anscheinend begünstigt.
Der Schimmel Gestank ist auch nicht gerade prinkelnt.
Im Souterrain jedenfalls keimt es immer mehr.
Alle Tomaten sind nun erfolgreich da, jetzt kommen noch die Sonderlinge dran und sogar ein Bull Paprika ist noch aufgegangen.
Somit ansonsten keine Ausfälle zu verzeichnen, sondern ausser meine Wenigkeit mit den Rocotos und der Chinese die 2 Monate im Wasser waren und völlig entkräftet nach der Pikierung eingegangen sind.
Werde nun bald die Samen säubern und dann in Erde pflanzen.
Mal wieder zu viel gewollt, obwohl keimen in Wasser mit Schnappsgläser fast immer ohne Schimmel geklappt hat.
Nur bei den Petrischalen nicht. Liegt wohl an zu wenig Wasserdruck pro mm, was Schimmel anscheinend begünstigt.
Der Schimmel Gestank ist auch nicht gerade prinkelnt.
Im Souterrain jedenfalls keimt es immer mehr.
Alle Tomaten sind nun erfolgreich da, jetzt kommen noch die Sonderlinge dran und sogar ein Bull Paprika ist noch aufgegangen.
Somit ansonsten keine Ausfälle zu verzeichnen, sondern ausser meine Wenigkeit mit den Rocotos und der Chinese die 2 Monate im Wasser waren und völlig entkräftet nach der Pikierung eingegangen sind.